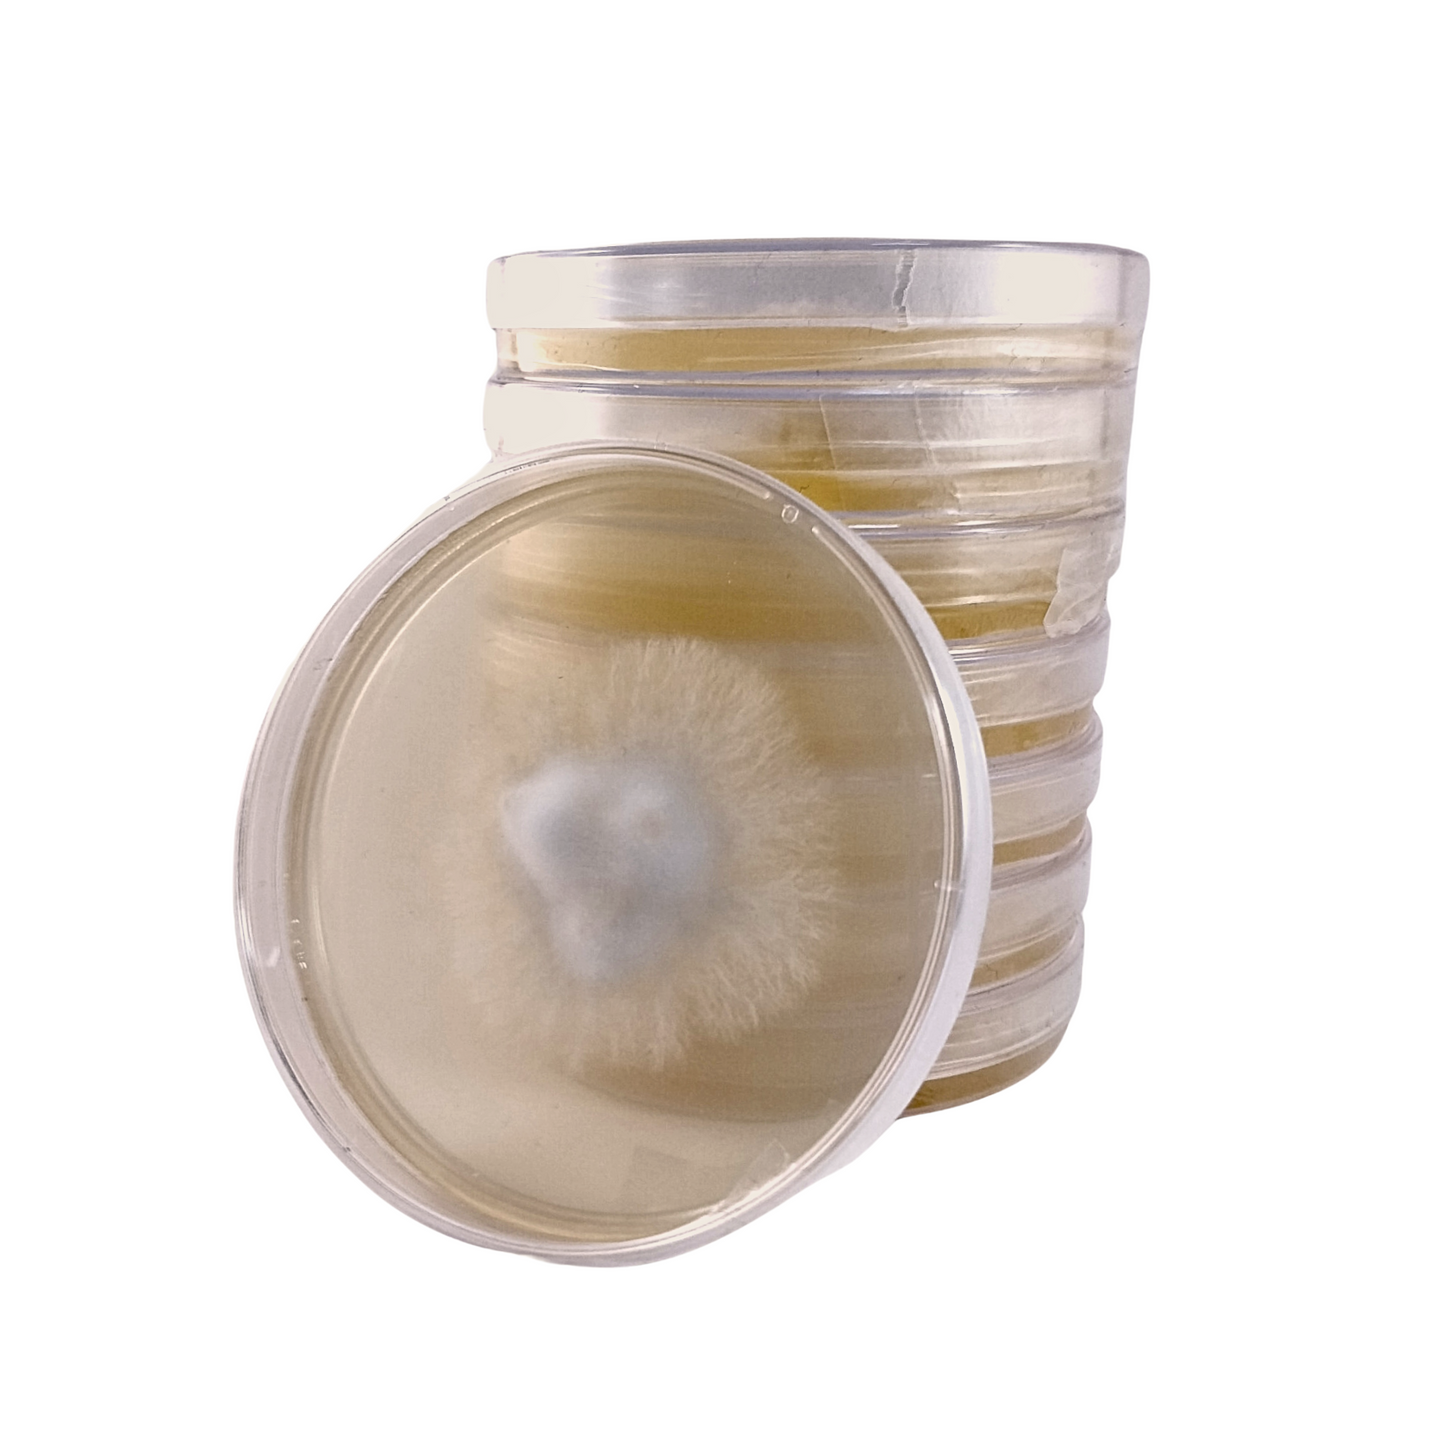

Urban Fungi
Pilzkultur auf Petri
Pilzkultur auf Petri
Verfügbarkeit für Abholungen konnte nicht geladen werden
Pilzkultur auf Agarplatte zum Animpfen verschiedener Medien
Unsere Pilz-Agar-Kultur ist ideal für die Beimpfung einer Vielzahl von Medien, einschließlich Getreide, Holz, Stroh, Samen, Agar und Lagerkulturen über einen längeren Zeitraum.
Wir beimpfen jedes Petri mit der von Ihnen ausgewählten Pilzsorte und senden es Ihnen zu. Es dauert etwa eine Woche, bis sich das Myzel vollständig auf der Petrischale angesiedelt hat.
Wählen Sie Ihre bevorzugten Kulturen aus unserer Liste aus (bitte hinterlassen Sie Ihre Sortenauswahl in den Bestellkommentaren)
*Perlenauster (Pleurotus ostreatus)
*Gelbe Auster (Pleurotus citrinopileatus)
*Königsauster (Pleurotus eryngii)
*Rosa Auster (Pleurotus djamor)
*Bittere Auster (Panellus stipticus)
*Shiitake (Lentinula edodes)
*Löwenmähne (Hericium erinaceus)
*Shimeji (Hypsizygus tessellatus)
*Waldhuhn (Laetiporus sulphureus)
*Kastanie (Pholiota adiposa)
*Cordyceps militaris (Cordyceps militaris)
*Chaga (Unbekannter Schrägstrich)
*Enoki (Flammulina velutipes)
*Brauner Champignon (Agaricus bisporus)
*Maitake (Grifola frondosa)
*Roter Reishi (Ganoderma Lucidum)
*Pappelauster (Pleurotus Calyptratus)
*Estragon-Auster (Pleurotus eunosmus)
*Rotweinhut (Stropharia rugosoannulata)
ACHTUNG! Jeder Petrischale liegt ein Stück Parafilm bei.
Compartir